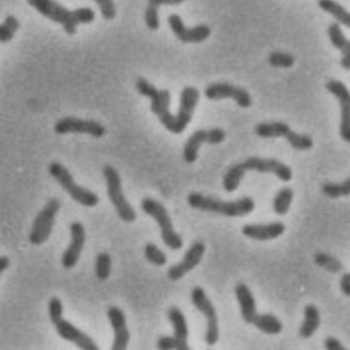

Alphabetical Index
American environmental microbiologist and scientific administrator, known for her research on global infectious diseases, water, and health, and for her pioneering work as the first female director of the National Science Foundation (NSF).
Bacillus subtilis is a robust, Gram-positive bacterium widely recognized for its adaptability and efficiency in various environments.
Overview of the Microbe Serratia fonticola is a Gram‑negative, rod‑shaped bacterium in the family Enterobacteriaceae, first described from freshwater habitats and now recognized in soils,...
Overview of the Microbe Serratia marcescens is a rod‑shaped, Gram‑negative bacterium within the family Enterobacteriaceae capable of aerobic and facultative anaerobic growth in diverse habitats,...
Discover Shakespeare, the timeless bard whose literary genius shaped English literature and continues to inspire countless generations.
Overview of the Microbe Streptomyces avermitilis is a Gram‑positive, filamentous actinobacterium first isolated by Satoshi Ōmura from soil in Shizuoka, Japan. Unlike most bacteria, it...
Overview of the Microbe Streptomyces lydicus De Boer et al. 1956 is a Gram‑positive, filamentous bacterium in the order Actinomycetales, isolated originally from soil in...
Overview of the Microbe Verticillium lecanii (Zimmermann) Viegas is an entomopathogenic fungus historically known for causing “white muscardine” disease in insects. It is now classified...
A portrait capturing whispers of wisdom and timeless elegance, blending experience and grace to create a compelling visual narrative.
Overview of the Microbe Xanthobacter autotrophicus is a Gram-negative, rod-shaped, aerobic bacterium in the family Xanthobacteraceae[1]. It was first isolated in the 1970s (originally named...